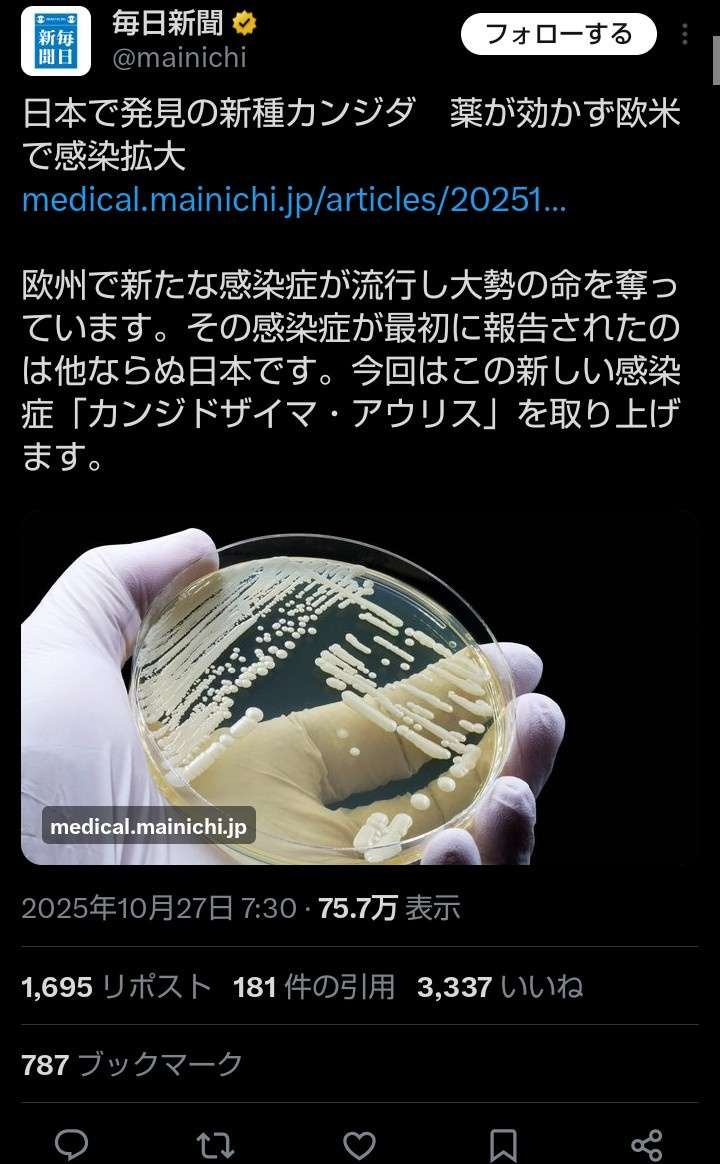

- 1 名前:ここからは表現の自由でイカせていただきます 投稿日時:2025/10/30(木) 15:03:10.58 ID:5IadgKn70
-
日本で発見の新種カンジダ 薬が効かず欧米で感染拡大
欧州で新たな感染症が流行し大勢の命を奪っています。その感染症が最初に報告されたのは他ならぬ日本です。今回はこの新しい感染症「カンジドザイマ・アウリス」を取り上げます。https://x.com/mainichi/status/1982575467925217599?t=KVWpvypj8PaxRaVxscbkvA&s=19
- 2 名前:ここからは表現の自由でイカせていただきます 投稿日時:2025/10/30(木) 15:04:23.74 ID:Hry7BXNZ0
- 🇯🇵の病院で熟成したのか😨
細菌攻撃してる🤮🤮
- 3 名前:ここからは表現の自由でイカせていただきます 投稿日時:2025/10/30(木) 15:05:00.86 ID:Fz/W+Fzp0
- 欧州で新種のカンジダが薬効かないってガチなんやな
これ世界的にやばいやつちゃうんか欧州で新種のカンジダが薬効かないってガチなんやなこれ世界的にやばいやつちゃうんか - 4 名前:ここからは表現の自由でイカせていただきます 投稿日時:2025/10/30(木) 15:05:01.98 ID:0EWyuSAQ0
- トーヨコ膣蠱毒で誕生したのかね
- 6 名前:ここからは表現の自由でイカせていただきます 投稿日時:2025/10/30(木) 15:05:27.25 ID:o7G9fm/Y0
- たちんぼで培養されただろこれ
- 7 名前:ここからは表現の自由でイカせていただきます 投稿日時:2025/10/30(木) 15:05:47.86 ID:y8cW9rmCM
- 日本が世界で活躍してるとか誇らしいな
- 8 名前:ここからは表現の自由でイカせていただきます 投稿日時:2025/10/30(木) 15:06:42.84 ID:4kc5no/O0
- 日本人の性欲は異常
- 9 名前:ここからは表現の自由でイカせていただきます 投稿日時:2025/10/30(木) 15:07:03.74 ID:k0My6Hqm0
- 吉原で流行ってたやつ
- 10 名前:ここからは表現の自由でイカせていただきます 投稿日時:2025/10/30(木) 15:07:08.45 ID:I36hl4Ma0
- メスジャップか
- 11 名前:ここからは表現の自由でイカせていただきます 投稿日時:2025/10/30(木) 15:09:06.77 ID:5IadgKn70
- 立ちんぼ国家日本で初めて発見されたのがこのジャップ菌『カンジダ・アウリス』
武漢肺炎とか言ってた日本人さんどうすんのこれ - 12 名前:ここからは表現の自由でイカせていただきます 投稿日時:2025/10/30(木) 15:09:35.46 ID:m2McsbMG0
- 立ちん坊のアソコで世界のカンジダから最強誕生
- 13 名前:ここからは表現の自由でイカせていただきます 投稿日時:2025/10/30(木) 15:14:06.94 ID:BlRRyVsoa
- またジャップが世界に迷惑かけたのか
有害ジャップ民族は絶滅しろよ - 14 名前:ここからは表現の自由でイカせていただきます 投稿日時:2025/10/30(木) 15:16:15.12 ID:VXznvjav0
- カンジダマ●コに入れたのか🤣
- 15 名前:ここからは表現の自由でイカせていただきます 投稿日時:2025/10/30(木) 15:16:33.20 ID:Bzd1TV/A0
- 中国のせいにしてるネトウヨいるけど日本っていつから中国になったの?
- 17 名前:ここからは表現の自由でイカせていただきます 投稿日時:2025/10/30(木) 15:17:15.32 ID:gZAcJC6n0
- ジャップランドでは流行ってないの?
- 18 名前:ここからは表現の自由でイカせていただきます 投稿日時:2025/10/30(木) 15:17:32.89 ID:GS1MORVv0
- 日本よ、日本のウイルスよ、世界の真ん中で咲き誇れぇ!!!
- 19 名前:ここからは表現の自由でイカせていただきます 投稿日時:2025/10/30(木) 15:18:22.30 ID:GBWEIMRt0
- たちんぼ買ったのがバレてしまうな
- 20 名前:ここからは表現の自由でイカせていただきます 投稿日時:2025/10/30(木) 15:18:26.67 ID:VXznvjav0
- 腐敗の花が咲いたよ〜
- 21 名前:ここからは表現の自由でイカせていただきます 投稿日時:2025/10/30(木) 15:19:38.80 ID:laQIiR5XH
- もう20年ぐらいたっただろ?
まだ薬できてないの? - 22 名前:ここからは表現の自由でイカせていただきます 投稿日時:2025/10/30(木) 15:19:45.68 ID:Ov79mAJg0
- 日本カンジダ
気持ち悪い
世界に迷惑かけるな - 23 名前:ここからは表現の自由でイカせていただきます 投稿日時:2025/10/30(木) 15:19:58.43 ID:WVxuQ3HoH
- 風呂で伝染るリスクある?
- 24 名前:ここからは表現の自由でイカせていただきます 投稿日時:2025/10/30(木) 15:23:10.89 ID:FblnEiUX0
- こういう菌は大体初期症状は風邪みたい感じなんだよな
外国は風邪で抗生物質出さないからこんな感じで広がっちゃうんだろ - 26 名前:ここからは表現の自由でイカせていただきます 投稿日時:2025/10/30(木) 15:27:28.70 ID:e2tsQvNF0
- >>24
皮膚病だからそういうのないだろ - 25 名前:ここからは表現の自由でイカせていただきます 投稿日時:2025/10/30(木) 15:27:01.72 ID:gyYR0eCh0
- ワクおじ悲報👧🏻
- 27 名前:ここからは表現の自由でイカせていただきます 投稿日時:2025/10/30(木) 15:31:00.85 ID:P9Ik14buM
- わからん
日本で広がらないのはどうして?
たちんぼを買うオジサンはたちんぼ以外とセクロスしないから? - 29 名前:ここからは表現の自由でイカせていただきます 投稿日時:2025/10/30(木) 15:33:36.19 ID:++mZNWm+0
- >>27
夜職の隔離が上手く行ってんだろうな。 - 28 名前:ここからは表現の自由でイカせていただきます 投稿日時:2025/10/30(木) 15:32:05.17 ID:HGPRKqSlH
- 海外に出稼ぎしてるからな
立ちんぼとか怖すぎて - 30 名前:ここからは表現の自由でイカせていただきます 投稿日時:2025/10/30(木) 15:38:59.77 ID:+/qdO+oq0
- 世界から集めた蠱毒みたいなもんやろ
- 31 名前:ここからは表現の自由でイカせていただきます 投稿日時:2025/10/30(木) 15:43:05.89 ID:DT6a/q56M
- ウイルスじゃなく真菌な
そして日本株と海外株はちょっと違う
発見されたのが日本ってだけですでに海外でも広がってた
ガチの『ジャップウイルス(日本カンジダ)』新種で薬が効かず欧州で感染拡大
嫌儲
嫌儲



コメント